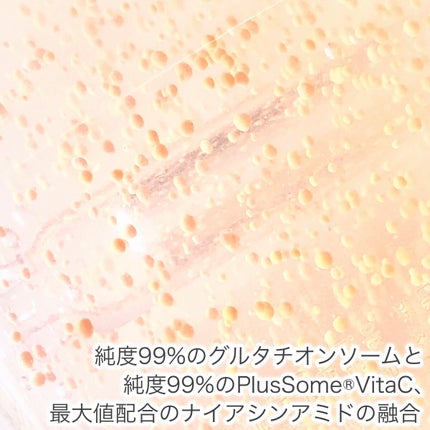
アビブ グルタチオンソームダークスポットセラムビタドロップ/Abib /美容液を使ったクチコミ(4枚目)

Abibアビブ🌼『グルタチオンソーム🧡ダークスポットセラムビタドロップ』50ml🪷とろんとしたテクスチャーですがべたつかず肌なじみがとても良いです🪷オレンジとホワイトのツブツブコアカプセルは気にならないくらいすぐに溶けてなくなりお肌に吸収して...
もっと見るおすすめアイテムAbib ×美容液
| 商品画像 | 商品情報 | 参考価格 | 評価 | ランキングIN | 特徴 | 商品リンク |
|---|---|---|---|---|---|---|
Abib グルタチオンソームダークスポットセラムビタドロップ | 2,970円 |
| とろりとジェルのようなテクスチャーですが 伸ばしやすく、とても肌馴染みがいいです! | 詳細を見る | ||
Abib 復活草ビフィダセラムファーミングドロップ | 2,970円 |
| 美容液ランキング第157位 | 肌なじみが良く、うるおい感があるのに肌表面はベタベタせずサラッとする感じがお気に入り🤍 | 詳細を見る | |
Abib ドクダミ エッセンス カーミングポンプ | 2,750円 |
| 肌にのせるとスーッと馴染む!!ベタつかなくて使用感とっても良いです💖 | 詳細を見る |
美容液ランキング
| 商品画像 | 商品情報 | 参考価格 | 評価 | ランキングIN | 特徴 | 商品リンク |
|---|---|---|---|---|---|---|
SHISEIDO アルティミューン™ パワライジング セラム | 9,900円(編集部調べ) |
| スキンケアランキング第6位 | スルスルっと伸びて、肌になじむとほんのりツヤ感を感じます。 後肌はさらり。 | 詳細を見る | |
DECORTÉ リポソーム アドバンスト リペアセラム | 12,650円 |
| スキンケアランキング第5位 | かたくなったしまった肌を柔らかくほぐしてくれるようなイメージでした! | 詳細を見る | |
Anua PDRNヒアルロン酸カプセル100セラム |
| スキンケアランキング第12位 | 水のようなサラッとしたテクスチャー 肌馴染み良くしっとりツヤ肌仕上がり 美容液使いはもちろん化粧水前の導入液としても◎ | 詳細を見る | ||
セタフィル セタフィル コンフォートリペア グロウセラム | オープン価格 |
| スキンケアランキング第13位 | 詳細を見る | ||
melnee メルニー ポジティブスキンセラム | 2,970円(編集部調べ) |
| スキンケアランキング第23位 | 詳細を見る | ||
ダルバ ダルバ ホワイトトリュフファーストスプレーセラム | 2,420円 |
| スキンケアランキング第4位 | ベタつきもなくしっとり保湿されたような感じです♪香水っぽい上品な香りがします。 | 詳細を見る | |
肌美精 肌美精 薬用美白美容液 [医薬部外品] | 1,441円 |
| スキンケアランキング第31位 | さらりとした使い心地♡ ベタつきはなくて使いやすかった❣️ 無香料なのも嬉しい | 詳細を見る | |
Torriden ダイブイン セラム | 2,420円 |
| スキンケアランキング第50位 | 肌にのせるとすぐにスッと馴染みます。馴染むとベタつかずすぐサラサラになる! | 詳細を見る | |
SK-II ジェノプティクス オーラ エッセンス | 20,900円(編集部調べ) |
| スキンケアランキング第37位 | シミ予防だけでなく、ツヤを与えてくれたりキメを整えてくれる効果も! | 詳細を見る | |
SOFINA iP ソフィーナ iP ベースケア セラム<土台美容液> | 5,500円〜 |
| スキンケアランキング第58位 | 見た目はふわっとしているのに、お肌にのせるとじゅわっと感じる濃厚泡。しゅわっととろけて馴染んでくれるような使い心地です。 | 詳細を見る |
Eririn🌹フォロバさんの人気クチコミ
プレステージのスキンケアが一式ライン使いできるオファーで、ゴールドの美しいBOXポーチにミニチュアが7点セットされており、とにかく眼福なんです😍💕 可愛くて可愛くてたまりません♥️ 内容がファンデーションのミニチュア→ル ネクター プレミエのミニチュアと内容までランクアップしているんです🥰💖
もっと見る
2156
47
- 2024.07.09
薔薇の摘み方のこだわりから魅力的な数値まで細かな説明でより一層欲しくなってしまいました🥹❤️ たっぷり使用してお肌ぷるっぷる🫧 チークはブラシを使わず、クッションのパフで付けていただいたのですが ナチュラルで綺麗な仕上がりにビックリ❣️
もっと見る
1709
25
- 2024.02.22
ディオールの4月1日〜スタートのバースデーギフトを受け取ってきました🎁✨ 実はこのセットを楽しみに、ネイルセットは受け取らずに待っていたんです🥰♥️ トートバッグのデザインが可愛すぎません?😍 トワルドゥジュイをベースにDIORを象徴するスター、世界地図にフランスから各国へ向けて赤い線で繋がれている素敵なデザイン🌎🩵 ルボームは大好きだし、リップグロウも保湿力高くて愛用しているので 使用頻度の高いアイテムのプレゼントは助かります🫶🏻♥️
もっと見る
1408
30
- 2024.04.02
カプチュールのオファーを入手しました🥰 1500円は安すぎてビックリします👀❣️もはやプチプラスキンケアのようなお値段になっていますね🤭 アイケアはアイセラムではなくアイクリームになっていました😍🩷 カプチュールを使用するとお肌のハリツヤがとても出るし、保湿もしっかりされるので手放せません🫶🏻
もっと見る
679
29
- 2024.03.12
¥500で試せる新作プリズムリーブルꕤ換えパフの値段より安い! プリズムリーブルの専用パフの価格が¥660なので、パフも付いているのにパフ単品よりもお安く手に入っちゃうの💓❤️ 夏の時期はサラッと使えるしヨレにくく崩れないので手放せません🧡
もっと見る
584
99
- 2024.08.16
輝く青ラメがとにかく可愛い♡透け感ラベンダーネイルꕤ ラベンダーのベースカラーに偏光青ラメがたっぷりと入っていて美しく輝きます🩵✨ ジルスチュアートのネイルはとってもお求めやすい値段なのも嬉しい🤭♥️
もっと見る
570
85
- 2024.09.13
商品詳細情報Abib グルタチオンソームダークスポットセラムビタドロップ
- ブランド名
- Abib (アビブ)
- 容量・参考価格
- 50mL: 2,970円
- 取扱店舗
- 近くのAbib 取扱店舗はこちら
- 商品説明
- 美白成分として人気を集めているグルタチオン成分を含んだグルタチオンソームシリーズ。 グルタチオンソームが詰まったコアカプセルが肌に触れた瞬間、弾けて浸透し 肌のくすみ、しみに集中アプローチ。 肌の透明感を高め、つるんとした綺麗な素肌に仕上げるカプセルセラム。
- メーカー名
- Fourcompany
- 発売日
- 2025/4/19
- カテゴリ
- スキンケア・基礎化粧品 > 美容液
- 成分
- <アビブ グルタチオンソームダークスポットセラムビタドロップ> 水、BG、ナイアシンアミド、1,2-ヘキサンジオール、コーンスターチ、トチャカエキス、ポリアクリレートクロスポリマー-6、ベタイン、クロレラエキス、グルコース、サトウキビエキス、(アクリレーツ/アクリル酸アルキル(C10-30))クロスポリマー、トロメタミン、アセチルグルコサミン、フルクトオリゴ糖、フルクトース、グリセリン、ペンチレングリコール、エチルヘキシルグリセリン、アラントイン、DPG、アデノシン、グルタチオン、EDTA-2Na、マデカッソシド、カルボマー、ヒドロキシプロピルメチルセルロース、水添レシチン、β-グルカン、コレステロール、酸化鉄、アシアチコシド、ツボクサ葉エキス、キトサン、アスコルビン酸、3-O-エチルアスコルビン酸、アスコルビルグルコシド、セラミドNP、リンゴ果実培養細胞エキス、トコフェロール、フェルラ酸、乳酸
![LIPS[リップス] - コスメのクチコミ検索アプリ](https://cdn.lipscosme.com/assets/lips_logo_full_2022-bc7b4bc9dd66035bc5696b0d16bc3d38a7be357186656c039e68cc4cf21ae675.png)

![肌美精 薬用美白美容液 [医薬部外品] / 肌美精](https://cloudflare.lipscosme.com/image/2025-08-18-4cfb0196040f7fd4d23cf632.png?auto=avif%2Cwebp&fio=1&orient=1&width=430)






































コメント